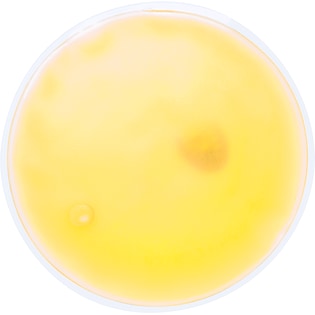
Heatpack Bisbee

Hugo Handvärmare
Heatpack i stickad påse. Hetapacken aktiveras genom att man trycker på metallplattan på dess insidan. Återaktiveras genom att läggas i varmt vatten.
Artikelnummer
32435
Mått
40 x 40 mm
Max tryckyta
40 x 40 mm
Material
polyester, PVC
Färger
svart, röd, beige
Produktblad
| Produkt | 25 st | 50 st | 100 st | 200 st | 300 st | 500 st |
|---|---|---|---|---|---|---|
| Hugo | 58 | 48 | 42 | 38 | 35 | 33 | Märkning |
| 1-färgstryck | 32 | 22 | 18 | 16 | 14 | 12 |
| 2-färgstryck | 64 | 44 | 36 | 32 | 28 | 24 |
| 3-färgstryck | 96 | 66 | 54 | 48 | 42 | 36 |
| 4-färgstryck | 128 | 88 | 72 | 64 | 56 | 48 |
| Tryckschablon: 350 kr/ färg. | ||||||
Hur beställer jag?
Du beställer lättast i vår webbshop. Den är mycket enkel att använda. Där laddar du upp din tryckfil. Det går också bra att maila din beställning till info@axonprofil.se
Får jag en skiss?
Självklart! Du får alltid godkänna en skiss och en offert innan din beställning blir bindande. Vill du se en skiss nu direkt? Skicka då bara din logga till oss och du har skissen hos dig inom någon timme.
Kan jag få ett prov?
Inga problem! Det löser vi.
Hur betalar jag?
Betalning sker mot faktura 30 dagar efter kreditprövning. Fakturering sker efter leverans. Kortbetalning är möjligt.
Vad är en tryckschablon?
Tryckschablonen är en slags mall som används vid tryckning. Vi måste ta fram en tryckschablon för varje färg som ska tryckas. Kostnaden för tryckschablonen försvinner när du repeatbeställer.
4,9/5
Baserat på 2 338 röster
Service med toppbetyg
Våra kunder har fått betygsätta vår nivå av service, och betyget talar för sig själv.
Testa själv att lägga en beställning så får du se hur berättigat vårt betyg är.